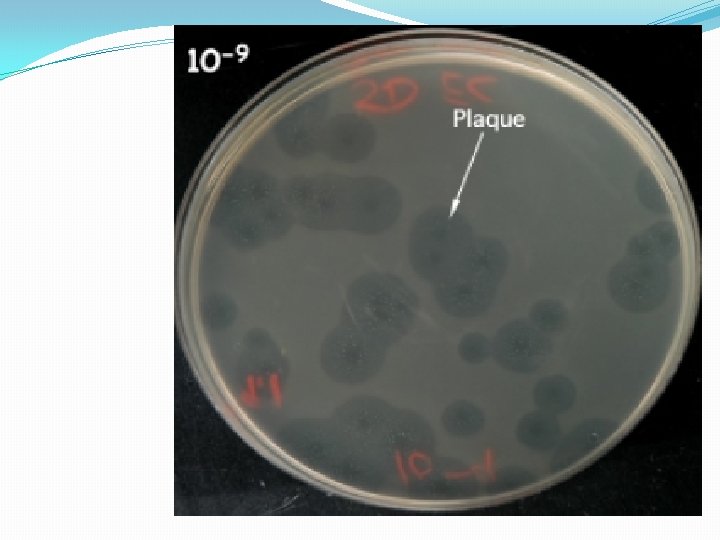

Gene Vectors part 1 Hams M A Mohamed

- Slides: 31
Gene Vectors (part 1) Hams M. A. Mohamed Assistant professor of Microbiology
1 -Plasmid � is a small, extrachromosomal DNA molecule within a cell that is physically separated from chromosomal DNA and can replicate independently. They are most commonly found as small circular, double-stranded DNA molecules in Bacteria ; however, plasmids are sometimes present in archaea and eukaryotic o. In nature, plasmids often carry genes that benefit the survival of the organism and antibiotic resistance.
�While chromosomes are large and contain all the essential genetic information for living under normal conditions, plasmids are usually very small and contain only additional genes that may be useful in certain situations or conditions. Artificial plasmids are widely used as vectors in molecular cloning, serving to drive the replication of recombinant DNA sequences within host organisms. In the laboratory, plasmids may be introduced into a cell via transformation.
Properties and characteristics of plasmid � 1 -Plasmids are replicate independently within a cell, in larger plasmids may carry genes specific for the replication of those plasmids. A few types of plasmids can also insert into the host chromosome, and these integrative plasmids are sometimes referred to as episomes in prokaryotes � 2 -Plasmids almost always carry at least one gene. Many of the genes carried by a plasmid are beneficial for the host cells, for example: enabling the host cell to survive in an environment that would otherwise be lethal or restrictive for growth. Some of these genes encode traits for antibiotic resistance or resistance to heavy metal,
� 3 - other Plasmids may produce virulence factors that enable a bacterium to colonize a host and overcome its defences or have specific metabolic functions that allow the bacterium to utilize a particular nutrient, including the ability to degrade recalcitrant or toxic organic compounds. Plasmids can also provide bacteria with the ability to fix nitrogen. Some plasmids, however, have no observable effect on the phenotype of the host cell or its benefit to the host cells cannot be determined, and these plasmids are called cryptic plasmids
� 4 -plasmids vary greatly in their physical properties. Their size can range from very small mini-plasmids of less than 1 -kilobase pairs (Kbp) to very large megaplasmids of several megabase pairs (Mbp). At the upper end, little differs between a megaplasmid and a minichromosome. Plasmids are generally circular, but examples of linear plasmids are also known. These linear plasmids require specialized mechanisms to replicate their ends.
� 5 -Plasmids may be present in an individual cell in varying number, ranging from one to several hundreds. The normal number of copies of plasmid that may be found in a single cell is called the Plasmid copy number, and is determined by how the replication initiation is regulated and the size of the molecule. Larger plasmids tend to have lower copy numbers. [7] Low-copy-number plasmids that exist only as one or a few copies in each bacterium are, upon cell division, in danger of being lost in one of the segregating bacteria. Such single-copy plasmids have systems that attempt to actively distribute a copy to both daughter cells. These systems, which include the par. ABS system and par. MRC system, are often referred to as the partition system or partition function of a plasmid.
Classifications and types of plasmid �Plasmids may be classified in a number of ways. Plasmids can be broadly classified into : 1 -conjugative plasmids and non-conjugative plasmids. Conjugative plasmids contain a set of transfer genes which promote sexual conjugation between different cells. In the complex process of conjugation, plasmids may be transferred from one bacterium to another via sex pili encoded by some of the transfer genes 2 -Non-conjugative plasmids are incapable of initiating conjugation, hence they can be transferred only with the assistance of conjugative plasmids. See Figure
�Another way to classify plasmids is by function. There are five main classes: �Fertility F-plasmids, which contain tra genes. They are capable of conjugation and result in the expression of sex pili. �Resistance (R) plasmids, which contain genes that provide resistance against antibiotics or poisons. Historically known as R-factors, before the nature of plasmids was understood. �Col plasmids, which contain genes that code for bacteriocins, proteins that can kill other bacteria. �Degradative plasmids, which enable the digestion of unusual substances, e. g. toluene and salicylic acid. �Virulence plasmids, which turn the bacterium into a pathogen. e. g. Ti plasmid in Agrobacterium tumefaciens
Function and uses of Plasmids �protein production Another major use of plasmids is to make large amounts of proteins. In this case, researchers grow bacteria containing a plasmid harboring the gene of interest. Just as the bacterium produces proteins to confer its antibiotic resistance, it can also be induced to produce large amounts of proteins from the inserted gene. This is a cheap and easy way of mass-producing the protein the gene codes for, for example, insulin.
�Gene therapy Plasmids may also be used for gene transfer as a potential treatment in gene therapy so that it may express the protein that is lacking in the cells. Some forms of gene therapy require the insertion of therapeutic genes at preselected chromosomal target sites within the human genome. Plasmid vectors are one of many approaches that could be used for this purpose. Zinc finger nucleases (ZFNs) offer a way to cause a site-specific double-strand break to the DNA genome and cause homologous recombination. Plasmids encoding ZFN could help deliver a therapeutic gene to a specific site so that cell damage, cancer-causing mutations, or an immune response is avoided. [19]
�Disease models Plasmids were historically used to genetically engineer the embryonic stem cells of rats to create rat genetic disease models. The limited efficiency of plasmid-based techniques precluded their use in the creation of more accurate human cell models. However, developments in adeno-associated virus recombination techniques, and zinc finger nucleases, have enabled the creation of a new generation of isogenic human disease models
2 -Bacteriophage • Bacteriophages ( phages ) are obligate intracellular parasites that multiply inside bacteria by making use of some or all of the host biosynthetic machinery. They are viruses that infect bacteria.
Composition of Bacteriophage �Nucleic acid: either DNA or RNA but not both �ds DNA, ss RNA, ss DNA �Unusual or modified bases �Encode 3 -5 gene products to over 100 gene products �Protein: Function in infection and protect the nucleic acid.
Structure of Bacteriophage Structure • Size – Head or capsid – Tail – Contractile Sheath Head/ Capsid Tail Fibers Base Plate
• Different sizes and shapes icosahedral filamentous
Phage genome • Encodes proteins needed for making more phages. • Double or single stranded DNA or RNA. • It can be circular or linear. For many phage types, the capsid is attached to a tail structure.
Types of Bacteriophage �Lytic or Virulent Phages. �Lysogenic or Temperate Phage. Lytic or virulent phages are phages which can only multiply in bacteria and kill the cell by lysis at the end of the life cycle. • Life Cycle – Adsorption – Penetration – Biological Synthesis – Maturation and Release
Life cycle of phage May occur as: • Lytic cycle which end up with lysis of bacteria • Lysogenic cycle(temperate cycle) in which phage DNA integrated into genomic DNA of bacteria. Also called temperate phage
1 2 3 5 4
Bacteriophage binding to and injecting their DNA into a bacterial cell
Bacteriophage after contraction of sheath io r te r o N m al c a b p ge a h
Assay for Lytic Phage Plaque assay
�Lytic phage are enumerated by a plaque assay. �A plaque is a clear area which results from the lysis of bacteria. �Each plaque arises from a single infectious phage. �The infectious particle that gives rise to a plaque is called a pfu (plaque forming unit).
�Lysogenic or temperate phages �Some phags fails to replicate or lyse the cell they infect. Their DNA is integrated in DNA bacterial chromosom and bass to daughter cell. the part o fphage DNA integrated at bacterial chromosome is called a prophage �The phage DNA in this repressed state because it is not a phage but it has the potential to produce phage. �The cell harboring a prophage is termed a lysogenic bacterium.
Lysogenic conversion �When a cell becomes lysogenized, occasionally extra genes carried by the phage get expressed in the cell. These genes can change the properties of the bacterial cell. This process is called lysogenic conversion. Outcome of the temperate cycle: 1 -the cell remain carring Prophage and pass to daughter cell 2 -the prophage may induced Uv or cold, …. And detatched from bacterial chromsome 3 - detatched prophage may carry apart of gentic material of host and transferd to new cell
Importance of bacteriophage in Bacteriological field: 1 - Phages are used in gene transfer through method called transduction. 2 - Phages are used in typing of many bacteria (phage typing). 3 -Used in treatment of bacterial infections. 4 -Used in molecular biology.